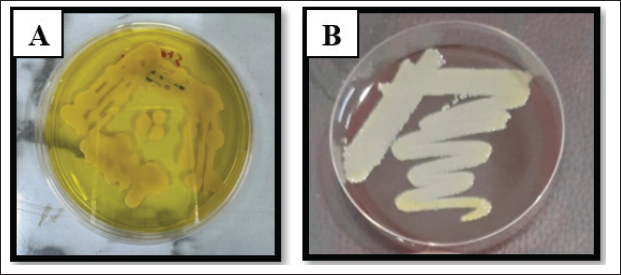
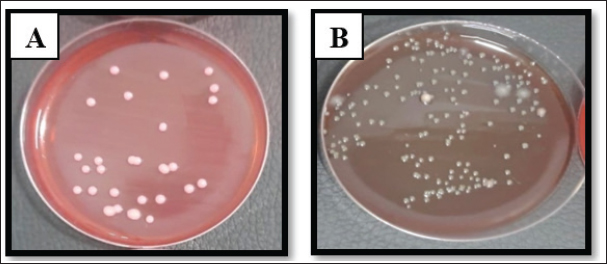

| Research Article | ||
Open Vet. J.. 2026; 16(1): 175-188 Open Veterinary Journal, (2026), Vol. 16(1): 175-188 Research Article New gel formulation for treating wounds infected with common bacteria isolated from feline wounds in ratsMena Mobasher Saleh* and Orooba Muhammad Saeed IbrahimDepartment of Physiology, Biochemistry and Pharmacology, College of Veterinary Medicine, University of Baghdad, Baghdad, Iraq *Corresponding Author: Mena Mobasher Saleh. Department of Physiology, Biochemistry and Pharmacology, College of Veterinary Medicine, University of Baghdad, Baghdad, Iraq. Email: mina.saleh2306m [at] covm.uobaghdad.edu.iq Submitted: 01/11/2025 Revised: 05/12/2025 Accepted: 09/12/2025 Published: 31/01/2026 © 2025 Open Veterinary Journal
AbstractBackground: The rising need for adjunctive plant-based wound therapeutics with anti-inflammatory, antibacterial, and prohealing properties stems from the growing concern of antibiotic-resistant wound infections in companion animals. Aim: To determine the main bacterial agents in feline wound infections and to test a new polyherbal gel made from Punica granatum peel, Rosmarinus officinalis leaves, and Cucurbita moschata fibers on Staphylococcus aureus-infected rat wounds model. Methods: VITEK-2 was used to confirm the results of culturing and blood, MacConkey, and Mannitol salt agars from veterinary clinics, blood collection camps in Baghdad. The plant materials were Soxhlet-extracted, and polyphenols were analyzed by high-performance liquid chromatography. There were five groups of rats, which included the non-infected control, the infected untreated control, the infected and 6% gel, the infected and 12% gel, and the infected and 2% fucidin. Carbopol gel with 6% (GF6%) and 12% (GF12%) total extracts was macerated and administered once a day for 10 days to excisional wounds infected with S. aureus (1.5 × 108 CFU/ml). The outcome measures were the percentage of wound contraction, absolute values of hydroxyproline (Hyp), ELISA values of vascular endothelial growth factor (VEGF), tumor necrosis factor-α (TNF-α), and histopathological examination Results: Staphylococcus aureus was the most prominent isolate (52.8% overall prevalence, most in accidental and postsurgical wounds). The extracts were rich in polyphenols, and GF12% (among other extracts) was able to achieve complete wound closure by day 10 (100%), whereas fucidin 2% and infected controls were 34% and GF6% 97%, respectively. GF12% greatly lowered VEGF and TNF-a levels relative to controls and fucidin while markedly elevating Hyp, suggesting increased collagen deposition. Histology after treatment with GF12% demonstrated orderly reepithelialization and collagen deposition akin to normal skin, whereas immature granulation and persistent inflammation were observed in fucidin-treated wounds. Conclusion: The polyherbal gel, especially at 12% concentration, had the most healing effect on wounds infected with S. aureus due to its powerful antibacterial, anti-inflammatory, collagen-restoring, and anti-angiogenic properties, presenting significant potential for topical use in veterinary wound care. Keywords: Cucurbita moschata, Punica granatum, Rosmarinus officinalis, Staphylococcus aureus, Wound healing. IntroductionIn the age of Antimicrobial resistance, bacterial infections of wounds in companion animals remain a substantial clinical and public health issue. Surveillance in various areas indicates the emergence of new pathogens in skin and soft tissue infections along with increased levels of multidrug resistance, which complicates clinical management and recovery (Chinemerem Nwobodo et al., 2022; Wang et al., 2024). From the human–animal–environment interface, metagenomic investigations, along with other studies, have increasingly documented the existence of AMR gene reservoirs and avenues for horizontal gene transfer, which amplifies the existing need for non-traditional antibiotics (Napita et al., 2025).Small animals commonly present with diverse (trauma, surgery, and bites) wounds that generate a variety of conditions that favor the colonization and infection from opportunistic and commensal bacteria that become resistant over time (Kožár et al., 2018; Lenart-Boroń et al., 2024). Among the major bacterial isolates, Staphylococcus aureus has a unique persisting challenge through direct cytopathic action on dermal fibroblasts and strong biofilm production that shields bacteria from the host’s immune and antimicrobial systems. Yokota et al. (2021) demonstrated that S. aureus can inhibit collagen production, which subsequently slows the remodeling phase of healing by disabling fibroblast migration. Roy et al. (2020) described how biofilm infection impairs collagen and granulation tissue construction in vivo, sustaining inflammation in unhealed or refractory wounds. These pathogen-induced deficits elucidate the inadequate debridement and topical care that fail without the accompanying strategies to both recover matrix dynamics and suppress the bacterial burden (Yokota et al., 2021). In attempts to alleviate the resistance to neutralizing bacterial microbes while aiding tissue reparation, novel interest in plants with antibacterial, anti-inflammatory, and matrix-stimulating properties has increased. Chojnacka and Lewandowska (2020) described how extracts with high concentrations of polyphenols can modulate the redox tone and neovascular signaling of chronic wounds, whereas Cioanca et al. (2025) documented how synergistic metal–polyphenol complexes dermally deliver and improve the bioactivity of topical applications. Tanideh et al. (2014) and Chinko and Precious-Abraham (2024) detailed how, in preclinical wound models of different botanicals, including various blends of Glycyrrhiza glabra preparations, re-epithelialization and exudate loss, as well as overall histologic maturation, improved as compared to the control, suggesting that there is a multi-modal mechanism congruent with the current demands of wound care (Chojnacka and Lewandowska, 2020). In this context, Punica granatum is prized as a potential topical application of wound healing therapy, which is attributed to the high degree of collagen supporting the organization of tissue, mediators, and inflammation that prevent bioactive tannins and flavonoids from eliciting a response. Stefanou et al. (2021) and Hemmati et al. (2020) reported narratives and explained experiments in which preparations based on pomegranate enhanced the closure rates of skin wounds and their histological quality in experimental animals. This applies to all types of injuries, including full-thickness skin defects. They also reported improved (better) epidermis continuity and dermal matrix alignment. The outcomes described above are consistent with the need to address the dysfunction in fibroblasts induced by S. aureus biofilms and the collagen deficits described. This suggests the use of pomegranate in integrative wound gels. The evidence strengthens the feasibility of clinical translation and goes as far as exploring the formulation of various plant gels and their synergistic use for treating infected wounds. Shahtalebi et al. (2018) and Aslani et al. (2018) documented that herbal gel vehicles containing several active plant components achieve reasonable stability and favorable user properties while also providing bioactive concentrations to the wound site. In infected animal models, the synthesis of phytochemical gels with other antimicrobial agents, including silver nanoparticles, antimicrobial peptides, and blue light, resulted in a significant reduction in the bio-burden of S. aureus with high resistance and an improvement in healing rates (Ibrahim et al., 2018). The integration of the complex AMR wound healing mechanisms of S. aureus in domestic animals, as well as S. aureus biofilm and complex plants rich in polyphenols (with S. aureus biofilm inhibition), warrants further investigation. This justifies the testing of poly-herbal gel systems that provide antibacterial control alongside matrix support to promote healing (Shahtalebi et al). The pomegranate peel, rosemary leaves, and pumpkin fibers were specifically selected because of their biochemical properties. Pomegranate contributes ellagic and gallic acids that facilitate collagen fibers. Rosemary contributes rosmarinic and caffeic derivative anti-inflammatory and antioxidants, while pumpkin comes with fractions more than rutin and p-coumaric that have effects on oxidation and restoratin of epithelium. With these properties, the constituents have a mixture of biochemicals that affect the anti-inflammation, extracellular matrix remodeling, and tissue healing. This study focused on the isolation and identification of the main bacterial agents that cause wound infection in cats, the determination of the healing effect of a newly formulated polyherbal gel, and the determination of its effects on wounds induced by S. aureus in the rat model. Evaluation was performed based on the wound contraction, collagen deposition, vascular endothelial growth factor (VEGF), and Tumor necrosis factor-α (TNF-alpha) levels, and histopathological healing of the wound. Materials and MethodsSample collectionFrom multiple vet clinics in Baghdad, Iraq, 125 clinical wound swabs were collected from cats from September to November 2024. Wounds were diagnosed as accidental, as well as surgical, tail, and local anal wounds, as described by the clinician. Swabs were collected under sterile conditions and placed in medium-sized transport tubes (Hiprove, China), where they were placed in cooled containers to maintain the microbial population. The samples were taken in less than 1 hour to the Microbiology Laboratory of the University of Baghdad, where they were strained and cultured. A temperature-controlled environment was maintained as samples were collected and taken to the laboratory to ensure that the samples’ preanalytical conditions remained consistent. Further cultural temperature variations in the samples would have resulted in false negatives from organisms that were very sensitive to temperature. Sample cultureThe described methodology resulted in each vet receiving swabs within a few hours. Each swab was placed on Blood Base Agar (HiMedia, India) to recover both hemolytic and nonhemolytic pathogens. Swabs were also placed on mannitol salt agar (HCM, China) and MacConkey agar (HiMedia, India) for selective and differential enteric gram-negative bacilli and staphylococci isolation. The resultant plates were incubated for up to 24 hours, after which the colony morphologies were observed. The preliminaries above need to eigenstate to be cultured for 16 hours on nutrient agar (HiMedia, India), incubated at 37°C. Distilled water is then slowly added to the system as it is identified and confirmed using the VITEK-2 system (bioMerieux, France). Automated biochemical identification and confirmation of primary wound colony isolates is performed at the species level. Collection of plantsBotanical materials—P. granatum (pomegranate) peel, Rosmarinus officinalis (rosemary) leaves, and Cucurbita moschata (pumpkin) fibers—were obtained from a taxonomically certified supplier based in Baghdad, Iraq, and verified by the Department of Biology, College of Science, University of Baghdad. Upon receiving the materials, the plant materials were washed with distilled water to rinse away foreign materials and contaminants that attach to the surface of the plant materials. The validated parts—peel, leaves, and fibers—were kept in air for 2 weeks to reach a stable moisture content suitable for solvent extraction and were then air-dried at room temperature. The purple parts were then milled into a uniform powder that was sieved (40-mesh) to optimize superlative penetration during Soxhlet extraction. Extraction of plantsIn a Soxhlet apparatus, powders of the respective plants were extracted for 6 hours using the indicated solvent systems and masses: leaves of the rosemary, 25 g in 80% ethanol (Merck, Germany); pomegranate peel, 20 g in 80% methanol (Merck, Germany); fibrous part of the pumpkin, 25 g in 50% acetone (ACS, US). Each of the solvent fractions was evaporated to concentrate the crude extracts for analytical testing. The choices of solvent were based on polarity differences that are essential to solubilize the predominant phenolics and terpenoids from each plant, and the evaporation temperature was kept low to avoid the breakdown of other heat-sensitive constituents. The concentrated extracts were kept in proper conditions until they were required for high-performance liquid chromatography (HPLC) profiling and gel preparation. HPLC evaluation of polyphenols in plantsThe polyphenolic extracts from the gel were profiled in HPLC at the Department of Environmental and Water Sciences, Ministry of Science and Technology in Iraq, using Sykam HPLC (Germany). The parameters for the analysis were set as follows: 100 µl of sample, refractive index detection at 280 nm, R-D 250-4.6: C-18-ODS (25 × 4.6 mm) for 1 ml of 250 nm R-methanol, 25 ml of distilled H2O, and 5 ml of formic acid at a flow rate of 1.0 ml/min. This HPLC-based technique allows the comparison of extracts and their contribution to the biological actions studied previously. This type of extraction allows the determination of the biological effects in vivo for each gel extract and allows the prediction of the physiological actions and activities of the gels. Preparation of the gel formulationsThe first formation fell under the GF-6% category. This formulation consisted of 2% w/w of each plant extract in a total of 6% w/w. Incorporating 4% w/w of each extract, the total reached 12% w/w, GF-12%. All samples were stored in triethanolamine, distilled water, propyl paraben, and glycerin. 5 ml of glycerin was added, and the mixture was combined with q.s. quantities of Carbopol 940 (1%). The mixture was thoroughly mixed until homogenized. The final gel was formed after Carbopol was neutralized with triethanolamine, providing an optimal pH for skin application. Preservatives and humectants were added to preserve skin moisture (Table 1). Table 1. Composition of herbal gel formulations F1 and F2.
Experimental designThe procedures in this study allowed achieving the objectives over the 10-day treatment period within 3 pre-defined phases, which are: 1, Assessment of the animal models post wounding (Table 2 and Fig. 1), 2, Assessment of the animals after infection, and 3, Assessment of the animals after treatment. All 10 animals in each of 5 groups were assigned to one of the 5 treatment groups; thus, 50 rats were used in the study. Group A: non-infected wound (negative control, CN); Group B: infected, non-treated wound (positive control, CP); Group C: infected wound treated topically with GF-6%; Group D: infected wound treated topically with GF-12%; Group E: infected wound treated topically with fucidin 2% (F-2%).
Fig. 1. Feline wound cases: A. Tail wound, B. Anal wound, C. Post-surgical wound, D. Accidental wound, E. Accidental wound , F. Accidental wound. Table 2. Samples of feline wounds categorized according to wound type.
The group size was selected based on a published paper to ensure statistical power while adhering to the ARRIVE and institutional ethical guidelines (Percie du Sert et al., 2020). Creation/induction of S. aureus-infected skin woundsSurgical anesthesia was achieved with the intramuscular administration of ketamine (90 mg/kg BW) and xylazine (40 mg/kg BW). A midline 10-mm full-thickness circular wound was created through the skin. The dorsal skin was clipped, shaved, and treated aseptically. A clinical sample of S. aureus was obtained by the VITEK-2 method and was confirmed as antibiotic-resistant. It was cultured in Mueller–Hinton broth (NDB, China) and was subsequently centrifuged (1,000 rpm, 15 minutes). The resultant pellet was resuspended in 10% phosphate-buffered saline to yield a concentration of 1.5 × 108 CFU/ml. 10 µl volumes were imparted to each wound surface. Treatments were initiated as soon as the wounds showed clinical signs of inflammation and infection, as is the usual practice with therapeutic initiation in infected wounds. Measurement of the wound diameterThe wounds were photographed and measured with a ruler at the exact moment of being created (day 1), 3 days post-infection, and subsequently at the 5 and 10 days post-treatment. All images were analyzed and calibrated on the same day to ensure that the images were in sync over the span of the analyzed frame. The percentage of wound contraction was determined as follows: contraction=(A0−At)/A0 × 100. Where A0 is the initial wound distance, and at is the distance at the respective time (day 3 post-infection and days 5 and 10 post-treatment). The tissue concentrations of VEGF, TNF-α, and hydroxyproline (Hyp) were estimated using rat-specific ELISA kits purchased from Simit, China, according to the manufacturer’s protocols. Because the sample time points were the same as the macroscopic wound evaluations, the biochemical shifts and wound healing were correlated by shape. The measured analytes were used as surrogate markers for VEGF (angiogenic activity), TNF-α (inflammatory activity), and Hyp (collagen deposition and remodeling) to provide a mechanistic perspective on the effects of the treatment on infected wound healing. Histopathological examination (H&E) of the skinUnder anesthesia, skin biopsies (1 × 1 cm squares centered around the wound) were collected at three time points: before wound induction, 3 days after infection, and 10 days after treatment. Specimens were fixed in formalin and sent for further analysis to the Histopathology Unit of the Department of Pathology and Poultry Diseases, College of Veterinary Medicine, University of Baghdad. Using a light microscope, the samples were stained with hematoxylin and eosin to observe the state of granulation tissue, the presence of new blood vessels, inflammation, and collagen, and the overall structural organization of healing to form the tissue. Statistical analysisThe Statistical Package for the Social Sciences (2019) was used to analyze the data. The treatment group and time effects were evaluated, and the mean was calculated using the two-way least significant difference method to check for statistical significance within and between groups. This method determines the main and interaction effects of the healing kinetics parameters in the infected wound model, which were expressed as mean ± SE and statistically significant according to the Least significant difference criteria specified in the results tables. Ethical approvalEthics statement All animal studies were conducted in accordance with universal ethical standards, taking into consideration animal welfare, so that they presented no more than slight discomfort, including, but not limited to, housing, anesthesia and analgesia, wounds, infection, treatment, sampling, and other procedures covering humane endpoints (Approval No. 13/P.G., dated January 5, 2025). All study procedures, including biopsy, euthanasia, and collection procedures within specified animal groups and intervals, were bound by protocol to minimize suffering and ensure the integrity of the study. The study procedures were followed to the letter. ResultsSample distributionOf the 125 feline cases studied, 125 cases displayed grossly inflamed wounds. This demographic included both mixed-breed males and females aged 3 months to 4 years. Representative cases showcased the different types of lesions via clinical photos. This aided in the case categorization that was used in the later analyses. In the current study, the most dominant case was accidental wounds, which amounted to approximately 48 cases (38.4%), followed by post-surgical complications, which amounted to 32 cases (25.6%), localized anal wounds, which amounted to 26 cases (20.8%), and tail wounds, which amounted to 19 cases (15.2%). The data confirm that trauma-linked injuries were the primary injuries dominant in this group. These proportions were the basis for the clinical context, which aided in understanding the prevalence of the treatments isolated from the bacteriology of the sample set. Bacterial isolationInclusions of cultures that the primary samples of the S. aureus showed the presence of different colonies, which facilitated the conclusion of their presence even before the automation process. S. aureus appeared to be colonized with a golden yellow color and was said to be producing on Blood Agar the β-hemolytic colonies. Escherichia coli, which was associated with pink and bright during the earlier stages, appeared to be moistened, grayish, and gaited on blood agar and then transformed to bright pink on MacConkey’s test. Klebsiella pneumoniae was the name that the last cluster formed, which appeared as grayish-white colonies that were mucoid in nature, while Blood Agar was pink in color and transformed into magenta on MacConkey. These data formed a very defining set of the most common pathogens. These distinct sets of phenotypic patterns that were found in culture panels were in opposition to the traditional laws of media selectiveness and different reactance. The laws then aided in the selection of representative colonies for further identification. The results of the culture analysis were the first hint that S. aureus was the most abundant species in this series, a suggestion that was later confirmed using VITEK-2 analysis (Figs. 2–4).
Fig. 2. Staphylococcus aureus on A. MS, and B. Blood agar.
Fig. 3. Escherichia coli on A. MacConkey agar. B. Blood agar.
Fig. 4. Klebsiella pneumoniae on A. MacConkey Agar. B. Blood agar. Identification of VITEK-2 systemS. aureus was the most abundant organism among all 125 isolates (52.8% of total) identified by the automated system, and the most abundant pathogens were found in accidental (66.66%) and postoperative (59.37%) wounds. Klebsiella pneumoniae and E. coli were in second place at 25.6% and 21.6%, respectively, with various distributions among the types of wounds, further supporting the clinical observation that Gram-positive cocci were the most common etiological agents in this population. The grouped matrix across the types of wounds highlighted the difference between risks in each setting: S. aureus was most frequently isolated from accidental and surgical wounds, whereas E. coli was more common in local anal wounds. These findings helped shape the subsequent in vivo work, in which S. aureus confirmed as VITEK resistant, was used to model infected wound healing under the trial therapies (Table 3). Table 3. Bacterial isolates derived from different wound types were subjected to identification test using the VITEK® 2 system.
Medicinal plant extractsExtraction resulted in the following characteristic preparations of each botanical: pomegranate peel (80% methanol) produced a viscous, dark red extract, rosemary leaves (80% ethanol) yielded an olive green extract with a spicy scent, and pumpkin fibers (50% acetone) yielded a golden-brown extract with a slight woody scent and a soft, tacky texture. The two carbopol-based topical gels (GF-12% and GF-6%) remained blurred before application. The clear differentiation between the two formulations enabled dose-response interrogation for the rat infectious model (Fig. 5).
Fig. 5. Physical appearance of A. GF 6%. B. GF 12%. Plant polyphenols (HPLC)The HPLC data corroborated the presence of a diverse range of polyphenols and flavonoids, such as rutin, ellagic acid, gallic acid, quercetin, ferulic acid, hydroxybenzoic acid, catechin, p-coumaric acid, and kaempferol, in the extracts. The high concentrations of gallic acid in the three botanicals (pomegranate, 165.9 ppm; rosemary, 102.6 ppm; and pumpkin, 95.8 ppm) and the high signals of ferulic acid and rutin justify the antioxidant and wound-modulatory properties of the gel. The variation in specific peaks between the plants illustrates the targeting of specific phenolic classes with solvent polarity, with rosemary and pumpkin having relatively higher quercetin/rutin signals and pomegranate being more ellagic/gallic rich. This composite fingerprint (Table 4) provides a biochemical basis for the multimodal actions observed in vivo. Table 4. Polyphenol analysis of plant extracts by HPLC.
Wound diameter and percentage of contractionThermal analysis indicated no differences within the groups at day 1; however, enhancements were observed for both gel groups at day 5, tapering off further to day 10, with GF-12% gel maintained optimal performance. The Negative Control demonstrated predicted no infection progression, substantiating the interval and contraction metrics timeline for the developed contraction metrics (Table 5). Table 5. Size of the wound area (mm2) and percentage of wound contraction in rats in different groups infected and treated.
All the groups, apart from the CN group, developed and peaked at infection on day 3, with the vertebrate endpoints showing fluently to the CN with 253 pg/gm and the vertebrate endpoints showing pathology on day 10. The activities of the 10th day indicated all groups apart from those indicated below with the GF-12% at 82.78 ± 0.46 pg/gm VEGF and 4.41 ± 0.45 pg/gm TNF-α. Analyzing the patterns the activities, exposed in the elephants was the focus of the three activities demonstrated through the inflammation pall at the vertebrate conditions to the zone of interest. The vertebrate group around gF-12% behaved off the predicted levels from fucidin, indicating the pall in the fucidin group and the sustained inflammation from the CP group omnipresent to what was noted in the previous collection. The confederation down-stages study represents those on the center level, indicating how multiple vertebrates demonstrated stability with the vertebrate endpoints, indicating how these samples can further indicate the vertebrate unit patterns to properly target the vertebrate endpoints from multiple vertebrate levels. The analysis of the vertebrate patterns exposed in the elephants was the focus of gF-12% Veteran, which targets important vertebrate biological activities coupled with wound closure. Both topics demonstrated anti-inflammatory and anti-angiogenic activities. The set-down activity of the vertebrate confederation down-stages study represents those on the center having vertebrate endpoints with base level indicating how multiple vertebrate endpoint vertebrate coordinates can indicate how target vertebrate unit vertebrate patterns from multiple vertebrate endpoint vertebrate controls. Gateway to collagen deposition was observed with the functional closure: in gel-treated wounds, Hyp rose sharply by day 10, with peaks in GF-12% (731.62 ± 0.39 ng/gm) and GF-6% (703.23 ± 0.47 ng/gm) exceeding the physiological remodeling of CN (603.23 ± 0.37 ng/gm) and strongly contrasting with CP (264.09 ± 0.87 ng/gm) and fucidin 2% (358.24 ± 0.63 ng/gm). The coordinated biochemical shifts consistent with macroscopic contraction (lower VEGF/TNF-α and higher Hyp) suggest rapid progression to the proliferative/remodeling phases of healing with Polyherbal treatment (Tables 6–8). Table 6. Tissue VEGF (pg/gm) in S. aureus-infected wounds treated with plant gel formula.
Table 7. Tissue TNF pg/gm in wounds infected with S. aureus and treated with a plant gel formula.
Table 8. Tissue Hyp (ng/gm) levels in S. aureus-infected wounds treated with plant gel formula.
Skin histopathologyThe presence of an intact epidermis, dermal collagen with fibroblasts/fibrocytes, organized dermis, and adnexal structures (hair follicles, sebaceous glands) verified normal architecture before the injury. After infection, slides from CP with severe abscessation showed histologic features of uncontrolled suppurative dermatitis beneath a bacterial load: a thick superficial fibrin clot, necrotic tissue, and dermal collagen overlaid by layers of polymorphonuclear leukocytes. In contrast, GF-6% therapy induced re-epithelialization with a dermis that showed maturing granulation tissue and with active but orderly angiogenesis and only a modest mononuclear infiltrate. However, GF-12% samples were closer to normal skin and showed a thin, mature epidermis over well-organized fibrous tissue that contained fibroblasts/fibrocytes and adnexa, which were fully restored. In contrast, the sections treated with fucidin 2% exhibited poorly formed re-epithelialization, extensive fibrin-necrotic debris, overdevelopment of blood vessels, and young scar tissue with moderate inflammation, which substantiated the worse biochemical and macroscopic results. (Figs. 6–10).
Fig. 6. (A) Section of skin (control group) shows: normal appearance of epidermis lining epithelial cells (e), normal dermal collagen fibers and cells (d), hair follicles (red arrow) with related sebaceous glands (black arrows) and sweat gland duct (blue arrow). H&E stain.100×. (B) Section of skin (control group) shows: normal appearance of epidermis epithelial cells (e), normal dermal collagen fibers (d), and fibroblasts (arrow). H&E stain.400×.
Fig. 7. (A) Section of the skin (infected group) shows: severe skin abscess with superficial fibrin clot formation (f), necrotic tissue (n), pus cells (black arrow), and dermatitis (d). H&E stain. (B) Section of skin (infected group) shows: severe skin abscess with thick layer of pus cells (arrows), necrotic tissue, and dermatitis (d). H&E stain.100×.
Fig. 8. (A) Section of the skin (treated with 6% gel formulation) shows: thin mature epidermis lining cells, (d) dermis with mature granulation tissue with many figures of angiogenesis, (v) and moderate infiltration of mononuclear leukocytes (arrows). H&E stain.100×. (B) Section of skin (treated with 6% gel formulation) shows: dermis with mature granulation tissue with many figures of angiogenesis and moderate infiltration of mononuclear leukocytes. H&E stain.400×.
Fig. 9. (A) Section of skin (treatment group with gel 12%) shows: thin mature epidermis lining cells and (d) dermis with normal mature granulation tissue with many figures of hair follicles (arrow). H&E stain.10×. (B) Section of skin (treatment group with gel 12%) shows: thin mature epidermis lining cells and (d) dermis with normal mature fibrous tissue with fibroblasts (black arrow) and fibrocytes (red arrow). H&E stain.400×.
Fig. 10. (A) section of skin treated with fucidin (2%) shows: superficial fibrin clot (black arrows), necrotic tissue with dead leukocytes (n), marked dermis angiogenesis (yellow arrow), and dermis immature granulation tissue with moderated infiltration of mononuclear leukocytes (red arrows). H&E stain.100×. (B) Section of skin dermis (treated with 2% Fucidin) shows marked angiogenesis (Mish work of blood vessels), immature granulation tissue with fibroplasia (red arrows), and moderate infiltration of mononuclear leukocytes (black arrows). H&E stain.400×. DiscussionThe prominent finding of S. aureus within S. aureus within these feline wounds wittilngly correlates with the findings of Wang et al. (2024), who identified S. aureus as one of the most clinically impactful resistance pathogens within skin and soft-tissue infections. This evidence corresponds exactly with the data of with Lenart-Boroń et al. (2024), who bafflingly highlighted the lack of wounds with staphylococci and the etiology of infected skin and soft tissue wounds. Reflecting on the One Health approach, these data gaps correspond with the antimicrobial resistance region that Chinemerem Nwobodo et al. (2022) investigated and reported on the human–animal interface and are similar to the works of Napita et al. (2025), who found numerous antimicrobial resistance gene reservoirs that complicate topical antibiotic treatment. The data from trauma and surgery S. Auri12 portions of our sample are more comparable to the works of Halicioglu et al. (2025) which study staphylococcal infection and delayed closure under conventional care to procedural and traumatic wounds. The overlap between more than eight languages on polyherbal formulation, having a statistically significant decrease of over 12% change in area regression growth rate of sore, is similar to the report of Stefanou et al. 2021 which states that interventions based on pomegranate help in the re-epithelialization of the skin, and collagen defects augment collagen-aligned cutaneous defects. In contrast to the study of Hemmati et al. (2020), the closure of the wound and the histological architecture of the pomegranate-treated group was better than that of the control group. Similarly, the phenolics of rosemary and pumpkin in our formulation are in line with the findings of Karthikeyan and Vidya (2019) who found that rosemary phenolics have antioxidant and skin-protecting properties, and with those of Ouyang et al. (2021) who found that plant matrices linked to ferulic and rutin provide polyphenols beneficial to matrix oxidative stress control and that ferulic- and rutin-linked preparations are helpful for oxidative stress and matrix stabilization. Altogether, the polyphenol literature indicating that the inflamed tissue reworking of the tissues is of a short duration, and the remodeling of tissues is of haste with the polyphenol abundant tapes is what the macroscopic gains to the tissue prove. The biochemical sequence of an initial increase followed by a severe suppression of values for VEGF and TNF-α, while Hyp increased, corresponds to an anticipated biochemical pattern for infected wounds that progress to organized repair. In particular, the VEGF/TNF-α declines align with Chojnacka and Lewandowska (2020), who noted that polyphenols modulate dysregulated angiogenic and inflammatory processes in chronic dermal injuries. It is also consistent with the findings of Tornese et al. (2024), who noted that pomegranate-derived interventions displayed antiangiogenic normalization. The antioxidant-matrix interest is also similar to what Merecz-Sadowska et al. (2021) described, in which flavonoids maintained fibroblast activity and stimulated collagen synthesis during oxidative stress. In addition, the pattern of polyphenol-mediated decrease in inflammatory load relative to collagen content is similar to that reported by Halicioglu et al. (2025) in which pomegranate constituents downregulated pro-inflammatory factors while assisting in tissue repair. Regarding the repair of collagen deposition and re-epithelization concomitantly with S. aureus, there is a restoration of complex function as described by Yokota et al. (2021) regarding the staphylococcal impairment of fibroblast migration and collagen production, which is the deficit that seemed countering by our gel. The histological normalization we observed is also reminiscent of Roy et al. (2020) who showed that biofilm-infected wounds have an inflammatory milieu that is disordered in granulation and deficient in collagen. Thus, our results agree with the idea that in infected wounds, therapy that combines both matrix-centered repair and bacterial suppression is required. Davidova et al. (2024) described this combined need with the tissue-level benefits of polyphenol antimicrobial actions that may relieve the selective pressure of described single-target antibiotics. Staphylococci were nearly exclusive in the current infected wound model, and the strong superiority of a phenolic polyherbal gel over a single-agent antibiotic is in line with several recent University of Baghdad studies, which provide a coherent One Health framework for infection control and tissue repair when taken together. From a veterinary perspective, our culture-first, confirmation-second approach parallels local bacteriological workflows and case mix complexity documented in equine strangles surveillance, where meticulous clinical sampling and laboratory verification were paramount in defining pathogen distributions (Abdul Latif and Yousif, 2025), and aligns with regional transboundary disease surveillance that has successfully isolated and typed high-consequence agents like SAT2 FMDV (Al-Anbagi and Allawe, 2025). The treatment contrast seen here—better closure, suppression of VEGF and TNF-α, and increased collagen—also resonates with formulation studies showing that locally manufactured gels can adequately target and deliver anti-inflammatory agents to sensitive tissues; in another organ system, ocular lornoxicam gel illustrated pharmaceutical efficacy and therapeutic promise, underscoring the application of gel-based drug delivery systems in mucocutaneous surfaces (Jafer and Kassab, 2025). The observation that biofilm-producing infections respond poorly to conventional therapies but improve with multi-target phytochemical approaches is analogous to data on canines with UTI that exhibit high biofilm persistence and multidrug-resistant infections caused by Pseudomonas aeruginosa (Jasim and Hayyawi, 2025). Sadeq et al. (2025a,b) documented that plant extracts can inhibit quorum sensing in K. pneumoniae to reduce biofilm and resistance associated with protracted infections. Mechanistically, the robust downregulation of VEGF observed under polyherbal therapy is comparable to an adjunct model in oncology where thyme-derived thymol nano-emulsions reduced VEGF/VEGFR expression, indicating that angiogenic signals/disturbances in different tissues under inflammatory stress can be recalibrated with botanicals (Hussein, 2025). Finally, in the same academic ecosystem, the public health dimension—the burden on health systems and the collateral antibiotic misuse risk—has been expounded with respect to human cohorts (Younis et al., 2025; Dawood et al., 2025). In contrast, our findings suggest that effective phytochemical treatments, which are available in our region, can reduce the use of antibiotics while enhancing clinical outcomes in veterinary wound care, which is in line with the laboratory outcomes and population-based stewardship documented in the University of Baghdad journals. The observation described above is also consistent with the use of adjunctive therapeutic agents, which have become scarce due to AMR, as exemplified by the therapeutic innovations advocated by Lenart-Boroń et al. (2024) and Wang et al. (2024). The latter advocated for reducing the antibiotic burden while simultaneously improving clinical outcomes. This gap can be filled with effective and multifunctional agents like the 12% gel, which incorporates all of the proposed design principles. Recent work by Cioanca et al. (2025), for instance, showed that polyphenol orchestrations and metal-phenolic interactions can modify properties and cutaneously enhance bioavailability and bioactivity. The results of this study are also comparable with those of the herbal gel work of Aslani et al. (2018), who reported effective dermal performance and stability within complex botanical mixtures, and with those of Shahtalebi et al. (2018), who reported appropriate polymer solutions with clinically relevant rheology and consistent active dispersion in carbopol systems. This body of work also supports its use in the adjunct management of wounds in veterinary practice complicated with resistant S. aureus. ConclusionThe model of wound infection in cats using dominantly S. aureus, in which animals were treated with different concentrations of a polyherbal gel made from P. granatum, R. officinalis, and C. moschata, showed acceleration in healing with a 12% formulation, which closed the wound completely by day 10. In relation to biochemistry markers, there was a lower level of VEGF and TNF-α and higher Hyp levels. In addition, histological studies showed features of reepithelialization and organized collagen. Infection control and Fucidin 2% were found to be positively correlated with healing macroscopically. These results indicate that the gel—especially the 12% formulation—can complement the standard topical antibiotics administered in cases of infected, resistant wounds, but can also be used instead of them. AcknowledgmentsThe authors thank the participating veterinary clinics in Baghdad for sample access and clinical coordination, and the College of Veterinary Medicine and affiliated laboratories for technical support in microbiology, HPLC, and histopathology. Conflict of interestThe authors have no conflicts of interest to declare. FundingThis research was self-funded. No external grants or sponsorships were received. Authors’ contributionsAll authors participated in the study. Data availabilityAll data were provided in the manuscript. ReferencesAbdul Latif, S.A.K. and Yousif, A.A. 2025. Clinical, bacteriological, and molecular study of Streptococcus equi isolated from horses in Baghdad, Iraq. Iraqi. J. Vet. Med. 49(1), 1–7; doi:10.30539/fk326b45 Aslani, A., Zolfaghari, B. and Fereidani, Y. 2018. Design, formulation, and evaluation of a herbal gel containing Melissa, sumac, licorice, rosemary, and geranium for treatment of recurrent labial herpes infections. Dental Res. J. 15(3), 191–200; doi:10.4103/1735-3327.231865 Chinemerem Nwobodo, D., Ugwu, M.C., Oliseloke Anie, C., Al-Ouqaili, M.T.S., Chinedu Ikem, J., Victor Chigozie, U. and Saki, M. 2022. Antibiotic resistance: the challenges and some emerging strategies for tackling a global menace. J. Clin. Lab. Anal. 36(9), e24655; doi:10.1002/jcla.24655 Chinko, B.C. and Precious-Abraham, A.D. 2024. Wound healing activity of hydromethanolic Dioscorea bulbifera extract on male Wistar rat excision wound models. Plant. Res. Med. Context. Mech. 11, 100425; doi:10.1016/j.prmcm.2024.100425 Chojnacka, K. and Lewandowska, U. 2020. The antiangiogenic activity of polyphenol-rich extracts and its implication on cancer chemoprevention. Food. Rev. Int. 36(1), 77–103; doi:10.1080/87559129.2019.1630634 Cioanca, O., Lungu, I.I., Batir-Marin, D., Lungu, A., Marin, G.A., Huzum, R., Stefanache, A., Sekeroglu, N. and Hancianu, M. 2025. Modulating polyphenol activity with metal ions: insights into dermatological applications. Pharmaceutics 17(2), 194; doi:10.3390/pharmaceutics17020194 Davidova, S., Galabov, A.S. and Satchanska, G. 2024. Antibacterial, antifungal, antiviral activity, and mechanisms of action of plant polyphenols. Microorganisms 12(12), 2502; doi:10.3390/microorganisms12122502 Dawood, H.N., Sameen, M.I. and Al-Khairalla, M. 2025. Radiological patterns of bronchogenic carcinoma in a sample of Iraqi patients. J. Fac. Med. Baghdad. 67(3), 288–293; doi:10.32007/jfacmedbaghdad2432 Halicioglu, I., Isiksacan, N., Baytekin, F., Kulus, M., Gulbagci, E., Inan, O. and Gunes, M.E. 2025. Effects of pomegranate on wound healing. Cureus 17(7), e89032; doi:10.7759/cureus.89032 Hemmati, A.A., Rashidi, I., Dahanzadeh, S. and Moeini, M. 2020. Investigating the healing effect of the hydroalcoholic extract of pomegranate seed (Punica granatum) on the full-thickness wound in rabbit. J. Contemp. Med. Sci. 6(2), 66–72; doi:10.22317/jcms.v6i2.715 Husain, W.M., Araak, J.K. and Ibrahim, O.M.S. 2019. Green synthesis of zinc oxide nanoparticles from (Punica granatum L.) pomegranate aqueous peel extract. Iraqi. J. Vet. Med. 43(2), 6–14; doi:10.30539/iraqijvm.v43i2.524 Hussein, A.H. 2025. Studying the effect of thymol-containing nano-emulsion extracted from thyme on angiogenesis-controlling genes VEGF and VEGFR in a human liver cancer cell line. Baghdad Sci. J. 22(4), 1151–1162. doi: 10.21123/bsj.2024.10591 Ibrahim, O.M.S., Ayad, Z.M. and Omar, L.W. 2018. Efficacy of silver nanoparticles, antimicrobial peptides and blue light combination on healing infected wound by methicillin resistant Staphylococcus aureus in rats. Kufa J. For Vet. Med. Sci. 9(2), 84–100; doi:10.36326/kjvs/2018/v9i24167 Al-anbagi, K.G. and Allawe, B.A. 2025. Isolation of SAT2 foot and mouth disease virus in Iraq. Iraqi. J. Vet. Med. 49(1), 16–22; doi: 10.30539/pnc4zf32 Karthikeyan, G. and Vidya, A.K. 2019. Phytochemical analysis, antioxidant and antibacterial activity of pomegranate peel. Res. J. Life. Sci. Bioinf. Pharm. Chem. Sci. 5(1), 218; doi:10.26479/2019.0501.22 Kožár, M., Hamilton, H. and Koščová, J. 2018. Types of wounds and the prevalence of bacterial contamination of wounds in the clinical practice of small animals. Folia. Vet. 62, 39–47; doi:10.2478/fv-2018-0036 Lenart-Boroń, A., Stankiewicz, K., Czernecka, N., Ratajewicz, A., Bulanda, K., Heliasz, M., Sosińska, D., Dworak, K., Ciesielska, D., Siemińska, I. and Tischner, M. 2024. Wounds of companion animals as a habitat of antibiotic-resistant bacteria that are potentially harmful to humans—phenotypic, proteomic and molecular detection. Int. J. Mol. Sci. 25(6), 3121; doi:10.3390/ijms25063121 Merecz-Sadowska, A., Sitarek, P., Kucharska, E., Kowalczyk, T., Zajdel, K., Cegliński, T. and Zajdel, R. 2021. Antioxidant properties of plant-derived phenolic compounds and their effect on skin fibroblast cells. Antioxidants 10(5), 726; doi:10.3390/antiox10050726 Omran, S.A. and Ghani, B.A. 2024. Immunohistochemical localization of epidermal growth factor receptor in rat buccal mucosa treated with fenugreek leaf oil. Iraqi J. Vet. Med. 48(2), 72–80; doi:10.30539/9hb0jd31 Ouyang, M., Cao, S., Huang, Y. and Wang, Y. 2021. Phenolics and ascorbic acid in pumpkin (Cucurbita maxima) slices: effects of hot air drying and degradation kinetics. J. Food Meas. Characterization 15(1), 247–255; doi:10.1007/s11694-020-00618-7 Percie Du Sert, N., Hurst, V., Ahluwalia, A., Alam, S., Avey, M.T., Baker, M., Browne, W.J., Clark, A., Cuthill, I.C., Dirnagl, U., Emerson, M., Garner, P., Holgate, S.T., Howells, D.W., Karp, N.A., Lazic, S.E., Lidster, K., Maccallum, C.J., Macleod, M., Pearl, E.J., Petersen, O.H., Rawle, F., Reynolds, P., Rooney, K., Sena, E.S., Silberberg, S.D., Steckler, T. and Würbel, H. 2020. The ARRIVE guidelines 2.0: updated guidelines for reporting animal research. PLos Biol. 18(7), e3000410; doi:10.1371/journal.pbio.3000410 Roy, S., Santra, S., Das, A., Dixith, S., Sinha, M., Ghatak, S., Ghosh, N., Banerjee, P., Khanna, S., Mathew-Steiner, S., Ghatak, P.D., Blackstone, B.N., Powell, H.M., Bergdall, V.K., Wozniak, D.J. and Sen, C.K. 2020. Staphylococcus aureus biofilm infection compromises wound healing by causing deficiencies in granulation tissue collagen. Ann. Surg. 271(6), 1174–1185; doi:10.1097/SLA.0000000000003053 Sadeq, J.N., Neamah, A.A., Aziz, A.A.A., Hussein, A.M. and Alsaedi, A.A. 2025. Isolation, identification and antimicrobial sensitivity of Klebsiella pneumoniae from bovine clinical mastitis cases. SAR J. Pathol. Microbiol. 6(3), 97–103; doi:10.36346/sarjpm.2025.v06i03.005 Tanideh, N., Rokhsari, P., Mehrabani, D., Samani, S.M., Sarvestani, F.S., Ashraf, M.J., Hosseinabadi, O.K., Shamsian, S. and Ahmadi, N. 2014. The healing effect of licorice on Pseudomonas aeruginosa-infected burn wounds in an experimental rat model. World. J. Plastic. Surg. 3(2), 99–106; Tornese, R., Montefusco, A., Placì, R., Semeraro, T., Durante, M., De Caroli, M., Calabrese, G., Caprifico, A.E. and Lenucci, M.S. 2024. Antiangiogenic potential of pomegranate extracts. Plants 13(23), 3350; doi:10.3390/plants13233350 Wang, C., Niu, X., Bao, S., Shen, W. and Jiang, C. 2024. Distribution patterns and antibiotic resistance profiles of bacterial pathogens among patients with wound infections in the Jiaxing region from 2021 to 2023. InfectDrug. Resist. 17, 2883–2896; doi:10.2147/IDR.S470401 Yokota, M., Häffner, N., Kassier, M., Brunner, M., Shambat, S.M., Brennecke, F., Schniering, J., Maggio, E.M., Distler, O., Zinkernagel, A.S. and Maurer, B. 2021. Staphylococcus aureus impairs dermal fibroblast functions with deleterious effects on wound healing. FASEB. J. 35(7), e21695; doi:10.1096/fj.201902836R Younis, M.S., Jassim, A.A., Ibrahim, H.W. and Khuraisan, A.A. 2025. Substance abuse among medical students in Baghdad: an updated concise descriptive study. J. Fac. Med. Baghdad. 67(3), 281–287; doi:10.32007/jfacmedbaghdad2429 | ||
| How to Cite this Article |
| Pubmed Style Saleh MM, Ibrahim OMS. New gel formulation for treating wounds infected with common bacteria isolated from feline wounds in rats. Open Vet. J.. 2026; 16(1): 175-188. doi:10.5455/OVJ.2026.v16.i1.17 Web Style Saleh MM, Ibrahim OMS. New gel formulation for treating wounds infected with common bacteria isolated from feline wounds in rats. https://www.openveterinaryjournal.com/?mno=293992 [Access: January 31, 2026]. doi:10.5455/OVJ.2026.v16.i1.17 AMA (American Medical Association) Style Saleh MM, Ibrahim OMS. New gel formulation for treating wounds infected with common bacteria isolated from feline wounds in rats. Open Vet. J.. 2026; 16(1): 175-188. doi:10.5455/OVJ.2026.v16.i1.17 Vancouver/ICMJE Style Saleh MM, Ibrahim OMS. New gel formulation for treating wounds infected with common bacteria isolated from feline wounds in rats. Open Vet. J.. (2026), [cited January 31, 2026]; 16(1): 175-188. doi:10.5455/OVJ.2026.v16.i1.17 Harvard Style Saleh, M. M. & Ibrahim, . O. M. S. (2026) New gel formulation for treating wounds infected with common bacteria isolated from feline wounds in rats. Open Vet. J., 16 (1), 175-188. doi:10.5455/OVJ.2026.v16.i1.17 Turabian Style Saleh, Mena Mobasher, and Orooba Muhammad Saeed Ibrahim. 2026. New gel formulation for treating wounds infected with common bacteria isolated from feline wounds in rats. Open Veterinary Journal, 16 (1), 175-188. doi:10.5455/OVJ.2026.v16.i1.17 Chicago Style Saleh, Mena Mobasher, and Orooba Muhammad Saeed Ibrahim. "New gel formulation for treating wounds infected with common bacteria isolated from feline wounds in rats." Open Veterinary Journal 16 (2026), 175-188. doi:10.5455/OVJ.2026.v16.i1.17 MLA (The Modern Language Association) Style Saleh, Mena Mobasher, and Orooba Muhammad Saeed Ibrahim. "New gel formulation for treating wounds infected with common bacteria isolated from feline wounds in rats." Open Veterinary Journal 16.1 (2026), 175-188. Print. doi:10.5455/OVJ.2026.v16.i1.17 APA (American Psychological Association) Style Saleh, M. M. & Ibrahim, . O. M. S. (2026) New gel formulation for treating wounds infected with common bacteria isolated from feline wounds in rats. Open Veterinary Journal, 16 (1), 175-188. doi:10.5455/OVJ.2026.v16.i1.17 |